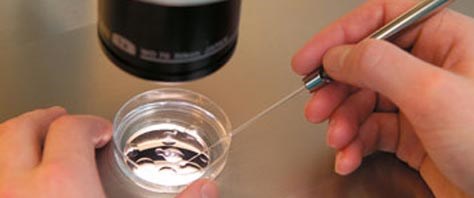
�Japon işi tüp bebek� Sağlık Haberleri NTV

Tüp bebek tedavisi öncesi rahimin değerlendirilmesi. From Pinterest
Tüp bebek ilaçları, vücudunuzdaki belli hormon seviyelerini artırarak, olgunlaşmaya ve her ay bir veya daha fazla yumurta.
Aniden, normal olmayan kilo artışı olması. Tüp bebek ilaçları kilo yapar mı diye soruyorsanız hastalardan gözlemlendiğine göre bazılarında iki tüp bebekte 3 kilo artışı bazı hastalarda da tek tüp bebek tedavisinde 5 kilo alımı gözlemlenmiştir. Tüp bebek ilaçları yan etkileri şu şekilde sıralanabilir. Tüp bebek tedavilerinde kullanılan ilaçları; Embriyoların anne adayının rahmine transfer edilmesinin ardından tutunmanın gerçekleşmesini desteklemek için progesteron ve östrojen hormonları verilir. Tüp bebek i̇laçları yukardaki örnekte toz halindeki tüp bebek ilaçlarına bir örnek gösterilmektedir tüp bebek de kullanılan ilaçlar çok çeşitli kategorilerde ve şekillerde olabilir.hastalarımız hepsini açıklamamızı isterse bu çok zor olur.bu yüzden genel bir bilgi vermek daha uygundur.

Tüp bebek tedavisi öncesi rahimin değerlendirilmesi.

Tüp bebek ilaçları nasıl uygulanır, yan etkileri var mıdır

Tüp Bebek İlaçları Kilo Yapar mı? Anne gram, 2020

Tüp bebek ve infertilite tedavilerinde kullanılan ilaçlar

Tüp Bebek Tedavisi Ne Kadar Sürer ? İstanbul Tüp Bebek

Tüp Bebek Başarı Hikayeleri ; Masal Değil Gerçekten…

Tüp bebek ilaçları nasıl uygulanır, yan etkileri var mıdır

Tüp bebek tedavisi öncesinde cevaplanması gereken 12 soru

Hayırlı Ramazanlar; Tüp bebek tedavisine Ramazanda nasıl

Her hafta instagramda tüp bebek psikolojisi yayını

Tüp Bebek Başarı Hikayeleri ; Kendinizi kimseyle kıyaslamayın.

Euro Star TV 2018 Ana Hatları Ile Kısırlık Tedavileri Ve

Tüp bebek tedavinizin ilk günü

Tüp Bebek Tedavisi Aşamaları Tüp Bebek Tedavisi Aşamaları

Tüp Bebek tedavilerinde yumurtaların artırılması tedavisi

ÇİDER Bakırköy’de Tüp Bebek Tedavileri Toplantısı yaptı.

Tüp bebek ve infertilite tedavilerinde kullanılan ilaçlar

Tüp bebek ilaçları nasıl uygulanır, yan etkileri var mıdır

Tüp bebek tedavisinin aşamaları nelerdir?

Tüp bebek Tedavileri Hasta Soru ve Doktor Cevapları26

Tüp Bebek Kıbrıs Kısırlık İlaçları euroCARE IVF Kıbrıs

Prof.Dr.Gökalp Öner Tüp Bebek Tedavisi ve Danışma Formu.

Tüp bebek tedavisi öncesinde cevaplanması gereken 12 soru

Tüp Bebek İlaçları İVF, ICSI Tüp Bebek Tedavisi

Tüp Bebek Tedavisi Ne Kadar Sürer ? İstanbul Tüp Bebek

Tüp bebek başarı hikayesi Vazgeçmeyin.

Tüp Bebek Tedavisi Nedir, Tüp Bebek Tedavi Süreci Nasıldır

Embriyo kalitesi mi yoksa sperm ve yumurta kalitesi mi?

Tüp bebek tedavisi öncesi rahimin değerlendirilmesi.

Tüp Bebek Tedavisinin Riskleri ve Komplikasyonları

Tüp bebek ile aşılama yöntemi arasındaki farklar nelerdir

Tüp Bebek Nedir?

Tüp Bebek Tedavisinde Hormon Değerleri

tüp bebek ilaçları kanser riskini arttırmaz YouTube
'Japon işi tüp bebek' Sağlık Haberleri NTV

Trabzon Medical Park Karadeniz Tüp Bebek Merkezi En İyi

Tüp Bebek İlaçları Kilo Yapar mı? Anne gram, 2020

Tüp Bebek Tedavisine Nasıl Hazırlanabilirsiniz?

Tüp Bebek Tedavisi Centre de FIV d'Istanbul






